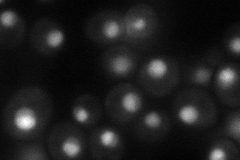
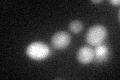

View description
Transcription factor involved in regulation of invasive growth and starch degradation; controls the activation of MUC1 and STA2 in response to nutritional signals
Localization:
Intensity:
Fold change:
Significance:
-
C’ GFP library in SD

nucleus19.35 -
N' NOP1pr-GFP in SD
nucleus42.2155 -
N' TEF2pr-mCherry in SD

missing0 -
N' NATIVEpr-GFP in SD

below threshold20.3489 -
N' TEF2pr-VC and Cyto-VN in SD

#N/A0 -
C’ GFP library in SD+DTT
nucleus19.431No -
C’ GFP library in SD+H2O2

nucleus19.881.02No -
C’ GFP library in Starvation Media

nucleus17.250.89No -
C’ GFP library on the background of Pup2-DaMP

nucleus -
C’ GFP library on the background of CCT mutant

nucleus19.61211.01303No
